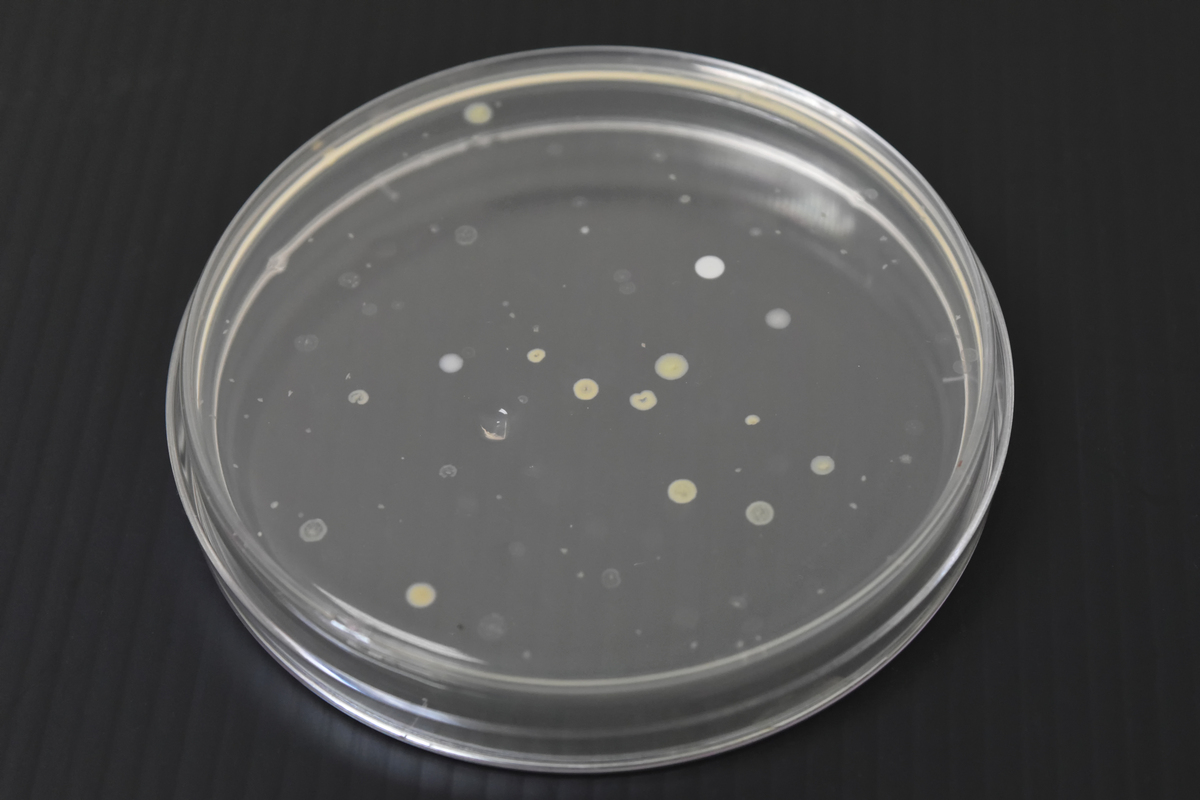
如何判断硝化细菌培养成功？

如何判断硝化细菌培养成功?
硝化细菌是一种重要的微生物,它们可以将氨氮转化为硝酸盐,从而起到净化水体和土壤的作用。因此,对硝化细菌进行培养非常重要。
要看硝化细菌是否成功培养,可以从以下几个方面进行判断:
-
观察细菌形态:硝化细菌通常是革兰氏阴性菌,形态多样,有棒状、球状、弧形等。在培养基上生长的细菌,可以通过显微镜观察其形态是否符合硝化细菌的特征。
-
检测生长速度:硝化细菌的生长速度较慢,一般需要7-10天左右才能形成较为明显的菌落。因此,如果培养基上出现了较为明显的菌落,且时间符合硝化细菌的生长周期,就可以判定为成功培养了硝化细菌。
-
测定硝化能力:硝化细菌的主要功能是将氨氮转化为硝酸盐,因此可以通过测定培养基中氨氮和硝酸盐的浓度变化来判断硝化细菌的硝化能力。如果培养基中的硝酸盐浓度增加,同时氨氮浓度下降,就可以证明硝化细菌成功培养。
总之,硝化细菌的培养需要耐心和细心,需要注意培养条件的控制和细菌的检测方法。只有在多个方面都符合硝化细菌的特征,并且能够表现出硝化能力,才能判定为成功培养了硝化细菌。
原文地址: http://www.cveoy.top/t/topic/lzUW 著作权归作者所有。请勿转载和采集!